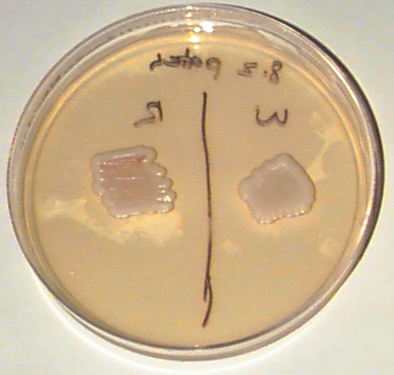

Red & White Yeast Continued:
Figure 2: Experiment 1: Patches from Red and White regions.
A dense sample of cells from the red region of the plate in figure 1 was smeared on a roughly square patch on the left-hand side of the plate below. The cells in that region were roughly as dense as at the start of the original patch (figure 1) - a dense, but barely-visible smear. A similar sample from the white region of the plate in figure 1 was smeared on the right side of this plate. This plate was incubated for 5 days at 30C.
Copyright 1996 Massachusetts Institute of Technology
Brian T. White